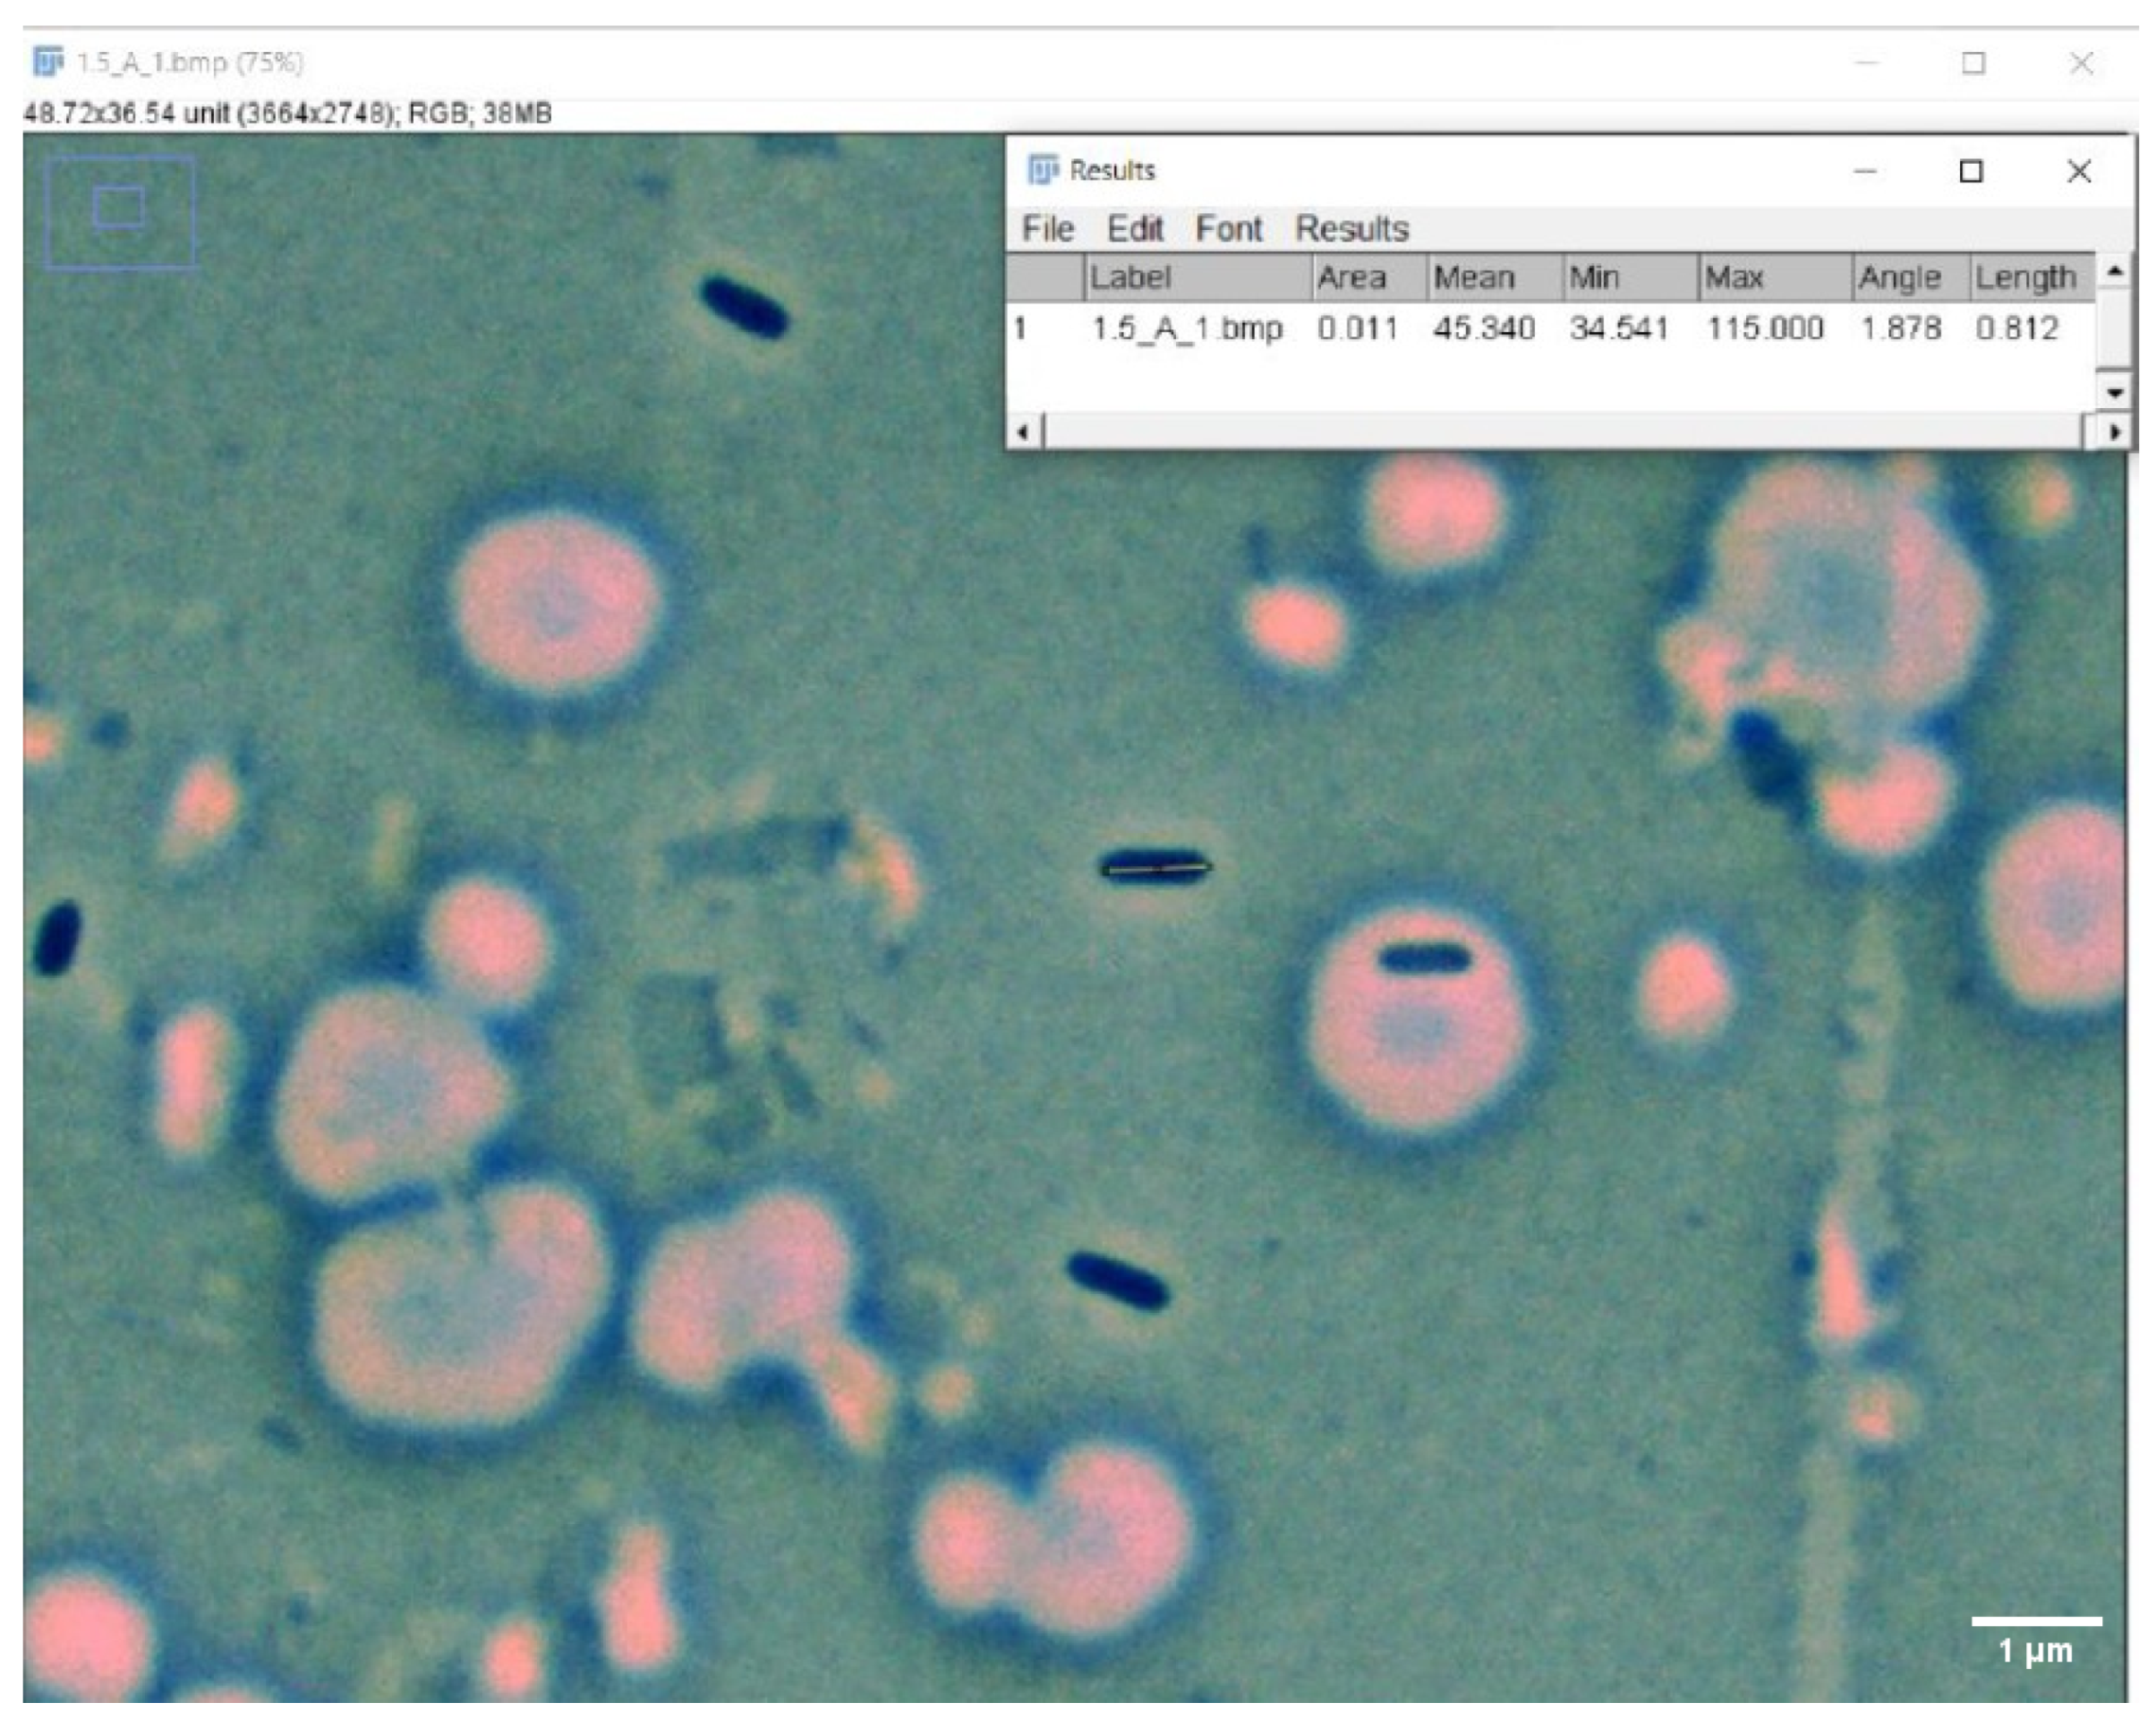
Microorganisms 12 00393 g003

Reduced Pseudomonas aeruginosa Cell Size Observed on Planktonic Cultures Grown in the International Space Station
Abstract
1. Introduction
1.1. Pseudomonas aeruginosa
1.2. Planktonic Cells
1.3. Cell Length and Diameter
1.4. Biofilms Project
2. Material and Methods
2.1. Sample Preparation
2.2. Microscopy and Photo-Sampling
2.3. Statistical Analysis
3. Results
3.1. LBK Results
3.1.1. Cell Length and Diameter Changes as a Function of Incubation Time and Gravity, Co-Cultured with LIS Coupon
3.1.2. Cell Length and Diameter Changes as a Function of Incubation Time and Gravity, Co-Cultured with p-SS316 Coupon
3.1.3. Cell Length and Diameter Changes as a Function of Incubation Time and Gravity, Co-Cultured with SS316 Coupon
3.2. mAUMg-High Pi Results
3.2.1. Cell Length and Diameter Changes as a Function of Incubation Time and Gravity, Co-Cultured with Cellulose Membrane Coupon
3.2.2. Cell Length and Diameter Changes as a Function of Incubation Time and Gravity, Co-Cultured with Silicone Coupon
3.2.3. Cell Length and Diameter Changes as a Function of Incubation Time and Gravity, Co-Cultured with Silicone-DLIP Coupon
4. Discussion
4.1. LBK Cultures
4.2. mAUM-High Pi Cultures
5. Conclusions
Supplementary Materials
Author Contributions
Funding
Data Availability Statement
Acknowledgments
Conflicts of Interest
References
- Chew, S.; Yang, L. Biofilms; Elsevier: Amsterdam, The Netherlands, 2016. [Google Scholar]
- Byloos, B.; Coninx, I.; Van Hoey, O.; Cockell, C.; Nicholson, N.; Ilyin, V.; Van Houdt, R.; Boon, N.; Leys, N. The impact of space flight on survival and interaction of Cupriavidus metallidurans CH34 with basalt, a volcanic moon analog rock. Front. Microbiol. 2017, 8, 671. [Google Scholar] [CrossRef]
- Mikkelsen, H.; Duck, Z.; Lilley, K.; Welch, M. Interrelationships between colonies, biofilms, and planktonic cells of Pseudomonas aeruginosa. J. Bacteriol. 2007, 189, 2411–2416. [Google Scholar] [CrossRef]
- Sauer, K.; Camper, A.; Ehrlich, G.; Costerton, J.; Davies, D. Pseudomonas aeruginosa displays multiple phenotypes during development as a biofilm. Am. Soc. Microbiol. 2002, 184, 1140–1154. [Google Scholar] [CrossRef]
- Crabbé, A.; Schurr, M.; Monsieurs, P.; Morici, L.; Schurr, J.; Wilson, J.; Ott, C.; Tsaprailis, G.; Pierson, D.; Stefanyshyn-Piper, H.; et al. Transcriptional and proteomic responses of Pseudomonas aeruginosa PAO1 to spaceflight conditions involve Hfq regulation and reveal a role for oxygen. Appl. Environ. Microbiol. 2011, 77, 1221–1230. [Google Scholar] [CrossRef]
- Weir, N.; Wilson, M.; Yoets, A.; Molina, T.; Bruce, R.; Carter, L. Microbiological characterization of the international space station water processor assembly external filter assembly S/N 01. In Proceedings of the 42nd International Conference On Environmental Systems, San Diego, CA, USA, 15–19 July 2012; p. 3595. [Google Scholar]
- Crabbé, A.; Nielsen-Preiss, S.; Woolley, C.; Barrila, J.; Buchanan, K.; McCracken, J.; Inglis, D.; Searles, S.; Nelman-Gonzalez, M.; Ott, C.; et al. Spaceflight enhances cell aggregation and random budding in Candida albicans. PLoS ONE 2013, 8, e80677. [Google Scholar] [CrossRef] [PubMed]
- Karunakaran, E.; Mukherjee, J.; Ramalingam, B.; Biggs, C. “Biofilmology”: A multidisciplinary review of the study of microbial biofilms. Appl. Microbiol. Biotechnol. 2011, 90, 1869–1881. [Google Scholar] [CrossRef] [PubMed]
- De Bentzmann, S.; Plésiat, P. The Pseudomonas aeruginosa opportunistic pathogen and human infections. Environ. Microbiol. 2011, 13, 1655–1665. [Google Scholar] [CrossRef] [PubMed]
- Pier, G.; Ramphal, R. Pseudomonas aeruginosa. Principles and Practice of Infectious Diseases; Churchill Livingstone: Philadelphia, PA, USA, 2004. [Google Scholar]
- Kim, S.; Lee, B.; Lau, G.; Cho, Y. IscR modulates catalase A (KatA) activity, peroxide resistance, and full virulence of Pseudomonas aeruginosa PA14. J. Microbiol. Biotechnol. 2009, 19, 1520–1526. [Google Scholar] [CrossRef] [PubMed]
- Basta, D.; Angeles-Albores, D.; Spero, M.; Ciemniecki, J.; Newman, D. Heat-shock proteases promote survival of Pseudomonas aeruginosa during growth arrest. Proc. Natl. Acad. Sci. USA 2020, 117, 4358–4367. [Google Scholar] [CrossRef] [PubMed]
- Li, H.; Dong, B.; Zhang, Z.; Zhang, H.; Sun, C. A transparent broadband ultrasonic detector based on an optical micro-ring resonator for photoacoustic microscopy. Sci. Rep. 2014, 4, 4496. [Google Scholar] [CrossRef] [PubMed]
- Xu, D.; Li, Y.; Gu, T. Mechanistic modeling of biocorrosion caused by biofilms of sulfate reducing bacteria and acid producing bacteria. Bioelectrochemistry 2016, 110, 52–58. [Google Scholar] [CrossRef] [PubMed]
- Javaherdashti, R.; Javaherdashti, R. Microbiologically Influenced Corrosion (MIC); Springer: Berlin/Heidelberg, Germany, 2017. [Google Scholar]
- Das, S.; Dash, H. Microbial Biotechnology—A Laboratory Manual for Bacterial Systems; Springer: Berlin/Heidelberg, Germany, 2014. [Google Scholar]
- Donlan, R.; Costerton, J. Biofilms: Survival mechanisms of clinically relevant microorganisms. Clin. Microbiol. Rev. 2002, 15, 167–193. [Google Scholar] [CrossRef]
- Coil, D.; Neches, R.; Lang, J.; Brown, W.; Severance, M.; Cavalier, D.; Eisen, J. Growth of 48 built environment bacterial isolates on board the International Space Station (ISS). PeerJ 2016, 4, e1842. [Google Scholar] [CrossRef]
- Zea, L.; Nisar, Z.; Rubin, P.; Cortesão, M.; Luo, J.; McBride, S.; Moeller, R.; Klaus, D.; Müller, D.; Varanasi, K.; et al. Design of a spaceflight biofilm experiment. Acta Astronaut. 2018, 148, 294–300. [Google Scholar] [CrossRef] [PubMed]
- Zea, L.; Larsen, M.; Estante, F.; Qvortrup, K.; Moeller, R.; Oliveira, S.; Stodieck, L.; Klaus, D. Phenotypic changes exhibited by E. coli cultured in space. Front. Microbiol. 2017, 8, 1598. [Google Scholar] [CrossRef]
- Ganguly, S. Characterization of Pseudomonas Aeruginosa Growth Patterns under Varying Gravitational Regimes; University of Colorado Anschutz Medical Campus: Boulder, CO, USA, 2018. [Google Scholar]
- Donachie, W.; Begg, K.; Vicente, M. Cell length, cell growth and cell division. Nature 1976, 264, 328–333. [Google Scholar] [CrossRef]
- Thi, M.; Wibowo, D.; Rehm, B. Pseudomonas aeruginosa biofilms. Int. J. Mol. Sci. 2020, 21, 8671. [Google Scholar] [CrossRef]
- Sanchez-Vizuete, P.; Dergham, Y.; Bridier, A.; Deschamps, J.; Dervyn, E.; Hamze, K.; Aymerich, S.; Le Coq, D.; Briandet, R. The coordinated population redistribution between Bacillus subtilis submerged biofilm and liquid-air pellicle. Biofilm 2022, 4, 100065. [Google Scholar] [CrossRef] [PubMed]
- Yoon, M.; Lee, K.; Park, Y.; Yoon, S. Contribution of cell elongation to the biofilm formation of Pseudomonas aeruginosa during anaerobic respiration. PLoS ONE 2011, 6, e16105. [Google Scholar] [CrossRef]
- Zhao, L.; Wang, X.; Chen, K.; Wang, Z.; Xu, X.; Zhou, X.; Xing, D.; Ren, N.; Lee, D.; Chen, C. The underlying mechanism of enhanced methane production using microbial electrolysis cell assisted anaerobic digestion (MEC-AD) of proteins. Water Res. 2021, 201, 117325. [Google Scholar] [CrossRef]
- Flores, P.; Schauer, R.; McBride, S.; Luo, J.; Hoehn, C.; Doraisingam, S.; Widhalm, D.; Chadha, J.; Selman, L.; Mueller, D.; et al. Preparation for and performance of a Pseudomonas aeruginosa biofilm experiment on board the International Space Station. Acta Astronaut. 2022, 199, 386–400. [Google Scholar] [CrossRef]
- Herrera-Jordan, K. Efectos de la Variación de Medios de Cultivo y Superficies de Crecimiento en las Dimensiones de Células Planctónicas de Pseudomonas aeruginosa, Cultivadas en la Estación Espacial Internacional Comparadas con Células Cultivadas en Gravedad Terrestre; Universidad del Valle de Guatemala: Guatemala City, Guatemala, 2022. [Google Scholar]
- Flores, P.; McBride, S.; Galazka, J.; Varanasi, K.; Zea, L. Biofilm formation of Pseudomonas aeruginosa in spaceflight is minimized on lubricant impregnated surfaces. Npj Microgravity 2023, 9, 66. [Google Scholar] [CrossRef]
- Luppens, S.; Reij, M.; Heijden, R.; Rombouts, F.; Abee, T. Development of a standard test to assess the resistance of Staphylococcus aureus biofilm cells to disinfectants. Appl. Environ. Microbiol. 2002, 68, 4194–4200. [Google Scholar] [CrossRef]
- Steinberger, R.; Allen, A.; Hansma, H.; Holden, P. Elongation correlates with nutrient deprivation in Pseudomonas aeruginosa-unsaturated biofilms. Microb. Ecol. 2002, 43, 416–423. [Google Scholar] [CrossRef]
- Zumft, W. Cell biology and molecular basis of denitrification. Microbiol. Mol. Biol. Rev. 1997, 61, 533–616. [Google Scholar]
- Ursell, T.; Lee, T.; Shiomi, D.; Shi, H.; Tropini, C.; Monds, R.; Colavin, A.; Billings, G.; Bhaya-Grossman, I.; Broxton, M.; et al. Rapid, precise quantification of bacterial cellular dimensions across a genomic-scale knockout library. BMC Biol. 2017, 15, 17. [Google Scholar] [CrossRef] [PubMed]
- Kim, W.; Tengra, F.; Young, Z.; Shong, J.; March, N.; Chan, H.; Pangule, R.; Parra, M.; Dordick, J.; Plawsky, J.; et al. Spaceflight promotes biofilm formation by Pseudomonas aeruginosa. PLoS ONE 2013, 8, e62437. [Google Scholar] [CrossRef]
- De Kievit, T. Quorum sensing in Pseudomonas aeruginosa biofilms. Environ. Microbiol. 2009, 11, 279–288. [Google Scholar] [CrossRef] [PubMed]
- Jiang, X.; Wang, H.; Shen, R.; Chen, G. Engineering the bacterial shapes for enhanced inclusion bodies accumulation. Metab. Eng. 2015, 29, 227–237. [Google Scholar] [CrossRef] [PubMed]
- Rollet, C.; Gal, L.; Guzzo, J. Biofilm-detached cells, a transition from a sessile to a planktonic phenotype: A comparative study of adhesion and physiological characteristics in Pseudomonas aeruginosa. FEMS Microbiol. Lett. 2009, 290, 135–142. [Google Scholar] [CrossRef] [PubMed]

| Cell Length Comparison | ||||||
|---|---|---|---|---|---|---|
| Day 1 | Day 2 | Day 3 | ||||
| Material Present in Culture | Shortest Length | Difference (%) | Shortest Length | Difference (%) | Shortest Length | Difference (%) |
| LIS | NS | NS | NS | NS | NS | NS |
| SS316 | *** | 4 | *** | 10 | NS | NS |
| p-SS316 | 1 g *** | 2 | *** | 10 | *** | 9 |
| Cell Diameter Comparison | ||||||
| Day 1 | Day 2 | Day 3 | ||||
| Material Present in Culture | Shortest Diameter | Difference (%) | Shortest Diameter | Difference (%) | Shortest Diameter | Difference (%) |
| LIS | NS | NS | NS | NS | NS | NS |
| SS316 | NS | NS | *** | 9 | *** | 1 |
| p-SS316 | NS | NS | *** | 10 | 1 g *** | 4 |
| Cell Length Comparison | ||||||
|---|---|---|---|---|---|---|
| Day 1 | Day 2 | Day 3 | ||||
| Material Present in Culture | Shortest Length | Difference (%) | Shortest Length | Difference (%) | Shortest Length | Difference (%) |
| Cell Memb | NS | NS | NS | NS | 1 g *** | 13 |
| Silicone | *** | 25 | *** | 4 | NS | NS |
| Silicone-DLIP | 1 g *** | 42 | NS | NS | *** | 25 |
| Cell Diameter Comparison | ||||||
| Day 1 | Day 2 | Day 3 | ||||
| Material Present in Culture | Shortest Diameter | Difference (%) | Shortest Diameter | Difference (%) | Shortest Diameter | Difference (%) |
| Cell Memb | *** | 12 | NS | NS | 1 g * | 6 |
| Silicone | *** | 15 | 1 g * | 5 | ** | 6 |
| Silicone-DLIP | *** | 32 | NS | NS | *** | 37 |
Disclaimer/Publisher’s Note: The statements, opinions and data contained in all publications are solely those of the individual author(s) and contributor(s) and not of MDPI and/or the editor(s). MDPI and/or the editor(s) disclaim responsibility for any injury to people or property resulting from any ideas, methods, instructions or products referred to in the content. |
© 2024 by the authors. Licensee MDPI, Basel, Switzerland. This article is an open access article distributed under the terms and conditions of the Creative Commons Attribution (CC BY) license (https://creativecommons.org/licenses/by/4.0/).
Share and Cite
Herrera-Jordan, K.; Pennington, P.; Zea, L. Reduced Pseudomonas aeruginosa Cell Size Observed on Planktonic Cultures Grown in the International Space Station. Microorganisms 2024, 12, 393. https://doi.org/10.3390/microorganisms12020393
Herrera-Jordan K, Pennington P, Zea L. Reduced Pseudomonas aeruginosa Cell Size Observed on Planktonic Cultures Grown in the International Space Station. Microorganisms. 2024; 12(2):393. https://doi.org/10.3390/microorganisms12020393
Chicago/Turabian StyleHerrera-Jordan, Katherinne, Pamela Pennington, and Luis Zea. 2024. "Reduced Pseudomonas aeruginosa Cell Size Observed on Planktonic Cultures Grown in the International Space Station" Microorganisms 12, no. 2: 393. https://doi.org/10.3390/microorganisms12020393
APA StyleHerrera-Jordan, K., Pennington, P., & Zea, L. (2024). Reduced Pseudomonas aeruginosa Cell Size Observed on Planktonic Cultures Grown in the International Space Station. Microorganisms, 12(2), 393. https://doi.org/10.3390/microorganisms12020393

